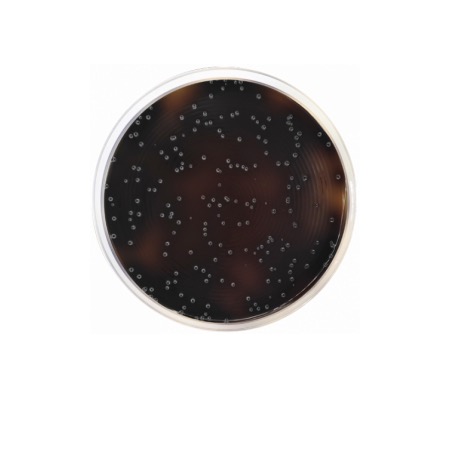

The medium is designed to support the growth of Listeria while suppressing the majority of accompanying flora. It contains a rich base of Peptones, Starch, and Sodium Chloride to provide essential nutrients and osmotic balance. Selectivity is achieved through the combination of Lithium Chloride and a specific antibiotic supplement (Oxford Supplement), which together inhibit the growth of Gram-negative bacteria and most Gram-positive organisms. The differentiation of Listeria species is based on the esculin hydrolysis. Listeria spp. hydrolyze esculin to glucose and esculetin; the latter reacts with Ferric Ammonium Citrate to form a black complex, resulting in brownish-black colonies surrounded by a black halo.
Advantages
- ISO Standard Compliance: Formulated in accordance with ISO 11290 for the horizontal method for the detection and enumeration of Listeria monocytogenes.
- High Selectivity: The high concentration of Lithium Chloride and the addition of antibiotics effectively minimize the growth of competitive bacteria like Enterococci and Staphylococci.
- Clear Differentiation: The blackening of the medium provides an unmistakable visual indicator for presumptive Listeria colonies.
- Reliable Performance: Optimized to recover even sublethally injured Listeria cells from complex food matrices.
- Versatile Use: Suitable for both clinical and industrial applications, particularly in dairy, meat, and environmental testing.
Technical specifications
| Catalogue number |
1133 |
| Brand |
Condalab |
| Application |
Detection and enumeration of Listeria monocytogenes (ISO 11290) |
| Typical Composition (g/L) |
Special Peptone (23.0); Starch (1.0); Sodium Chloride (5.0); Lithium Chloride (15.0); Esculin (1.0); Ferric Ammonium Citrate (0.5); Bacteriological Agar (10.0) |
| Final pH (at 25 °C) |
7.0 ± 0.2 |
| Preparation |
55.5 g/L (Add Oxford Supplement) |
| Storage Temperature |
2 – 25 °C |
Available packaging options
| 1133 |
500 g plastic bottle |